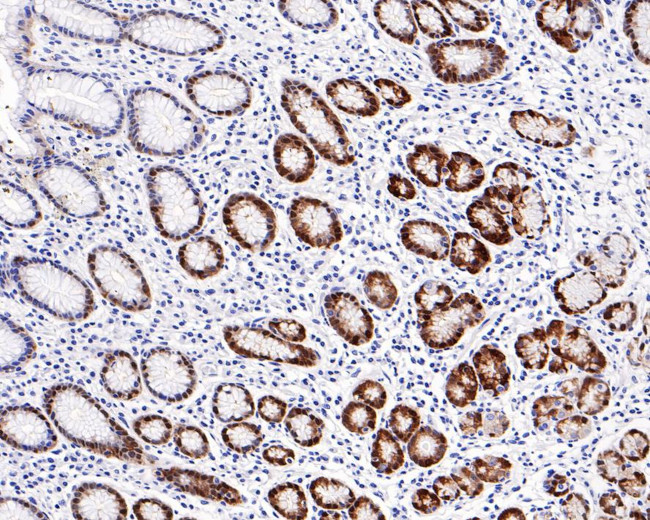
ALDH3A1 Antibody in Immunohistochemistry (Paraffin) (IHC (P))

Search
Invitrogen
ALDH3A1 Recombinant Rabbit Monoclonal Antibody (PD00-73)
{{$productOrderCtrl.translations['antibody.pdp.commerceCard.promotion.promotions']}}
{{$productOrderCtrl.translations['antibody.pdp.commerceCard.promotion.viewpromo']}}
{{$productOrderCtrl.translations['antibody.pdp.commerceCard.promotion.promocode']}}: {{promo.promoCode}} {{promo.promoTitle}} {{promo.promoDescription}}. {{$productOrderCtrl.translations['antibody.pdp.commerceCard.promotion.learnmore']}}
图: 1 / 4
ALDH3A1 Antibody (MA5-50726) in IHC (P)




Please note: We are reviewing Western blot images included in the antibody testing data in our catalog, including those provided by third parties. Unless expressly labeled or annotated as “raw-unedited”, Western blot images included in the antibody testing data in our catalog may have been edited, optimized or otherwise adjusted for presentation.
产品信息
MA5-50726
种属反应
宿主/亚型
Expression System
分类
类型
克隆号
抗原
偶联物
形式
浓度
规格
纯化类型
保存液
内含物
保存条件
运输条件
RRID
产品详细信息
Positive control: A549 cell lysate, human skin tissue lysate, human lung tissue, human esophagus tissue, human stomach tissue.
Predicted band size: 50 kDa
Subcellular Location: Cytoplasm.
靶标信息
Aldh3A1 is a member of the aldehyde dehydrogenase superfamily, a group of NAD(P)(+)-dependent enzymes that catalyze the oxidation of a wide spectrum of aliphatic and aromatic aldehydes. Aldh3A1 is highly expressed in stomach and even more strongly in cornea, representing between 5 to 50% of the water soluble protein fraction in mammalian corneas. It is thought that Aldh3A1 acts to protect the cornea from UV-induced oxidative stress by not only detoxification of reactive aldehydes by also through the direct absorption of UV energy. However, corneas from Aldh3A1-null mice are indistinguishable from those from wild-type mice; mice lacking both Aldh3A1 and Aldh1A1 showed increased cataract formation following UVB exposure, suggesting that Aldh1A1 may be able to compensate for the loss of Aldh3A1.
仅用于科研。不用于诊断过程。未经明确授权不得转售。
篇参考文献 (0)
生物信息学
蛋白别名: Aldehyde dehydrogenase 3; Aldehyde dehydrogenase family 3 member A1; Aldehyde dehydrogenase, dimeric NADP-preferring; ALDHIII; MGC10406
基因别名: ALDH3; ALDH3A1
Entrez Gene ID: (Human) 218